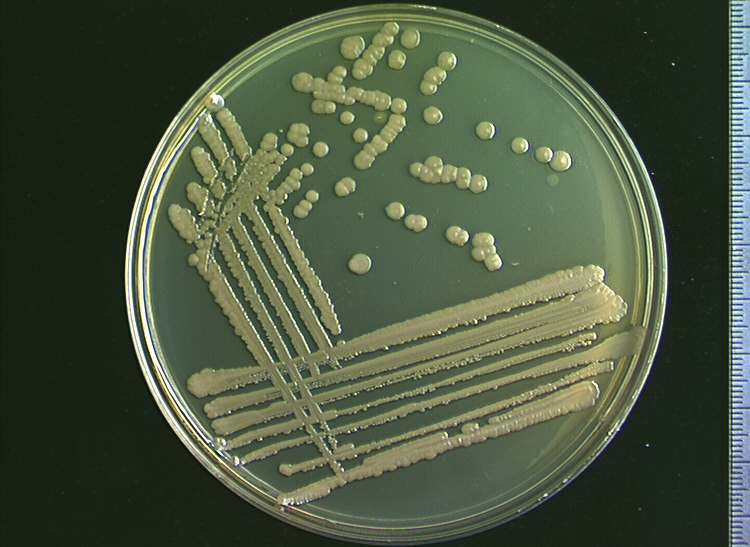
顯微鏡下的脲芽孢八疊球菌。圖片來源：Alchetron

日本四國島南部的高知縣,很不巧的就位於即將可能發生海溝型地震的不定時炸彈――南海海槽上方,因此當地可說是時時刻刻都處在地震與海嘯的威脅下。海溝型地震發生的原因,乃是由大陸地層(阿穆爾板塊)受海洋地層(菲律賓海板塊)下沉影響,發生強烈錯動。海水也會隨著地殼隆起而被擠出來,形成海嘯。
而位於該縣南國市的國立海洋研究開發機構「高知地核研究所(海洋研究開発機構高知コア研究所)」,正進行著這個有望緩和海底地層隆起幅度與海嘯強度的夢幻研究――將細菌注入兩斷層邊界一公尺深的淺層縫隙,以細菌在海中生成的碳酸鈣當作水泥,填補並固定板塊間的縫隙。
細菌在這個防災措施乃是不可或缺的:由於黏度低,易於植入斷層縫隙,便能夠讓它們在其中大範圍地增殖、擴張地盤,產生碳酸鈣的結晶。研究團隊比較了四種細菌在岩石上附著的情況,發現其中「脲芽孢八疊球菌」(Sporosarcina ureae)在生成結晶上最為活躍。
而在利用「摩擦試驗機」施加與斷層內相同程度壓力、重現地殼邊界運動的實驗中,注入細菌的石頭,其不易移動與滑出的程度都各增加了一成。這種防災措施能夠一口氣抑制板塊邊界的錯動,顯然其減輕海嘯的能力確實具有一定成效,備受期待。
這個防災方案是由現年31歲的年輕研究員濱田洋平所提出,並在去年三月正式開始進行研究。然而,在可行性依然未知的當下,研究團隊還有許多課題需要解決――例如要如何將細菌注入板塊斷層等等――在他們認真摸索下,可行性也正逐漸解明。
「這個方案距離實用化還很遙遠。但是,我們正在進行增加岩石強度的研究,有朝一日能減輕海嘯也不是不可能的。」濱田洋平如此說道。
資料來源:HUFFSPOT、每日新聞、TOCANA